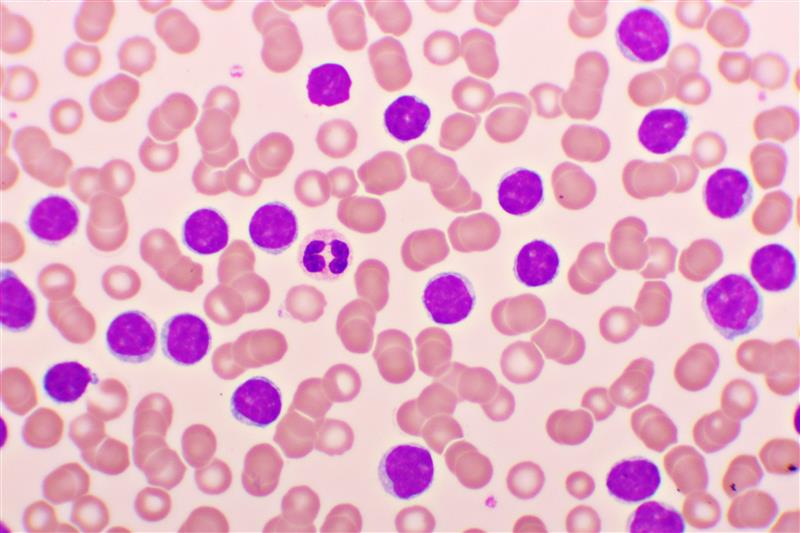

Authors: Eva Loizou, PhD, Customer Success Manager; Andreas Dimakakos, PhD, MBA, PMP, Director of Scientific Insights; Bara Badwan, PhD, Senior Data Scientist
Before the 66th Annual ASH Annual Meeting and Exposition—the premier event in classical and malignant hematology—2024 kicked off in San Diego, we analyzed a subset of biotech companies with promising programs*. We analyzed our vast, expertly curated clinical and biological data, historical benchmarks and patented AI-driven probability of technical and regulatory success (PTRS) assessments to highlight a subset of high-potential programs and make predictions proactively**.
While AI isn’t a crystal ball, when expertly curated, AI-ready data, expertise and patented AI methodologies are combined – the output certainly lends itself to trusted, predictive power. We’re pleased to share our pre-ASH predictions and the post-ASH results. We accurately highlighted programs that uniformly all released positive outcomes, further supporting the effectiveness and reliability of our method. In this blog, we’ll highlight what biotechs topped our list, along with a look into our methodology, what ASH confirmed, and how such AI-driven insights can drive value in your organizations.
Our process for pre-ASH predictions with company scores and AI-driven PTRS insights
By leveraging our AI-driven PTRS assessments, we highlighted a subset of companies – specifically five biotechs — that we predicted would stand out at ASH. We started with the complete universe of companies with currently active oncology programs. We continued to filter this data, which was set down by those with liquid cancer programs, non-big pharma companies, companies potentially presenting at ASH, and finally, top companies ranked based on our patented PTRS methodology. From there, we came up with a list of 12 sponsors, and from those 12, we narrowed it down to 5 companies by looking at programs with the highest PTRS amongst peer groups and expert knowledge for each program.
This resulted in a list of five companies we’ll highlight in more detail: Nurix Therapeutics, Sellas Life Sciences, Kura Oncology, Arcellx Inc., and Poseida Therapeutics.

1. Nurix Therapeutics | A Novel BTK Degrader With Potential to be Best-in-Class

Drug Characteristics
• NX-5948, a tyrosine-protein kinase BTK (Bruton’s Tyrosine Kinase) degrader, is being developed for B-cell malignancies.
• NX-5948 is not a traditional BTK inhibitor but a BTK degrader that uses targeted protein degradation to eliminate the BTK protein altogether, rather than just blocking its activity. This approach can offer improved efficacy and may overcome resistance mechanisms arising from mutations (e.g., C481S mutation) that develop with conventional BTK inhibitors. This could also lead to fewer off-target effects, thus limiting potential toxicities.
• Despite the novel nature of the compound, its action type (Tyrosine-protein kinase BTK Inhibitor) has been quite successful in the past, positively affecting the PTRS of this program.
Positive Clinical Trial Characteristics: The program is rewarded for the number of therapy-treated patients and the fact that the trial recruited all the patients it had initially announced.
Regulatory Designations: The program received a fast-track designation on January 16, earlier this year, which is also a major positive predictor for a program this early in its development.
2. Sellas Life Sciences | High-PTRS AML Program Targeting WT1 via a Novel Modality With Early Success

Drug Characteristics:
• Galinpepimut-S (GPS) is an immunotherapeutic agent designed to target WT1, a protein overexpressed in many cancers. The therapy has shown promise in maintenance therapy settings, particularly for AML patients in complete remission after second-line salvage therapy (CR2).
• Despite its potential, GPS has not yet achieved any regulatory approvals, even though it has been evaluated in two prior programs targeting multiple myeloma and mesothelioma. Moreover, therapies utilizing its underlying action type — WT1-protein activator—have been extensively tested across various tumor types without successfully gaining approval, something that strongly penalizes the PTRS.
Early Results: Early efficacy results from Ph2 indicate a potential survival benefit, with the study’s primary endpoint being overall survival. Adjustments to the trial design, such as increasing enrolment and refining statistical analyses, suggest confidence in the drug’s potential efficacy.
Regulatory Designations: The program received fast track (2016-06-06) and orphan drug (2015-12-23) designations, which are major positive predictors of its success.
In addition to Galinpepimut-S that we had highlighted, Sellas Life Sciences announced results for their Phase 1/2 SLS009 CDK9 inhibitor trial, combined with azacitidine and venetoclax in relapsed/refractory acute myeloid leukemia (AML) patients after prior venetoclax treatment. Among 29 evaluable patients, 31% achieved a clinical response, with higher efficacy observed in patients with ASXL1 mutations (56% response rate) which will become the focus for the AML-MR subpopulations.
3. Kura Oncology | Potential Best-in-Class Menin Inhibitor With Unique Properties to Expand Patient Access and Overcome Resistance Mechanisms

Drug Characteristics:
• Ziftomenib is a menin inhibitor, targeting specific mutations such as NPM1 and KMT2A rearrangements in patients with AML.
• This is a novel compound with no approval or failures thus far, negatively impacting the program’s PTRS. However, a distinguishing characteristic of this menin inhibitor, in comparison with its competitors, is that it can inhibit the mutant menin proteins as well, which makes it unique.
Early Results: This first-in-class menin inhibitor has shown encouraging efficacy in the KOMET—001 trial. A patient achieved complete remission for over two years and undetectable disease, while demonstrating a manageable safety profile.
Regulatory Designations: Ziftomenib has been granted breakthrough therapy by the FDA, which boosts its PTRS.
4. Arcellx | Multiple Myeloma Front-Runner Program Based on PTRS

Drug Characteristics:
• Arcellx’s proprietary D-domain binder offers a differentiated mechanism for targeting BCMA (B-cell maturation antigen), a validated target in multiple myeloma therapies with multiple approvals, which positively affects this program’s PTRS.
• Manufacturing and Scalability: Kite has assumed responsibility for the manufacturing process, emphasizing quality, reliability, and scalability, which are critical for CAR T-cell therapies
Early Results: In Phase 1 trials, anito-cel has shown promising results in heavily pretreated patients, including those with triple—and penta-refractory disease. The therapy achieved significant overall response rates in these challenging populations, which is a major positive signal for this program’s PTRS.
Regulatory Designations: The FDA has designated it a fast-track and orphan drug, reflecting its potential as a significant advancement in treatment for these patients.
5. Poseida Therapeutics | Rapid Allogeneic T-cell Therapy With 100% ORR in Select Patient Cohorts Addressing an Unmet Need

Drug Characteristics:
• P-BCMA-ALLO1 is an allogeneic CAR-T cell therapy targeting BCMA for treating relapsed/refractory multiple myeloma with a good safety and tolerability profile. A key benefit is its “off-the-shelf” nature, as it is an allogeneic cell therapy tool with quick administration without needing patient-specific cell collection and engineering. The median time from enrolment to infusion was just one day.
• Despite this compound being novel with no failures nor approvals, the action type (Tumor necrosis factor receptor superfamily Binding Agent) has been quite successful in MM with four prior approvals, which rewards the PTRS of this program.
Early Results: The early-phase clinical trials have shown promising results with certain trial arms, achieving a 100% overall response rate (ORR) even in heavily pretreated patient populations. This is reflected in the positive PTRS impact by the efficacy overall signal.
Regulatory Designations: This program received an orphan drug designation in December 2023, positively affecting its PTRS.
Predictions With Confidence: Post-ASH Results Confirmed Our Pre-ASH Predictions
After ASH came to a close and readouts were finalized, we went back to the five highlighted companies. Quite notably, we were spot on with all five of our predictions, as each of the biotech companies had breakthrough positive outcomes at ASH. The snapshot below summarizes the precision and accuracy of our predictions.

- The companies we selected ran programs that ranked amongst the best within their peer group, considering the same indication and phase of development.
- These programs featured distinctive and innovative assets, positioning them as standout candidates expected to make an impact at ASH.
- We precisely placed these programs at the top before any results were publicly released.
This success underscores the reliability of our PTRS assessments as robust predictors of early program success, enhancing confidence in their utility for future predictions.
Here’s Why This Matters: Drive Value for Your Organization By Integrating Our Innovative Approach
The need for timely, data-driven and trusted results to inform key decisions at all points in drug development is no secret. Our spot-on predictions with ASH serve as a proof point of the insights we can drive to de-risk drug development.
- Enhanced Decision-Making: Quickly identify high-potential programs within your portfolio, focusing resources on the most promising opportunities. Save time and effort by focusing only on standout programs with innovative assets, maximizing your ROI.
- Smarter Investments: Minimize risk by leveraging reliable, AI-driven predictions to guide strategic choices.
- Proven Reliability for Data-Driven Insights: Have confidence in our PTRS assessments, which have demonstrated a strong track record of accurately predicting success before public outcomes.
- Competitive Edge: Gain early insights that position you ahead in a highly competitive landscape.
For even more predictive and actionable insights, discover how our data, AI-driven PTRS assessments and biology-trained experts can elevate and guide your strategic decision-making, let’s talk.
*A program (also known as clinical pipeline or drug pipeline) is the clinical development of a drug (or a set of drugs in case of combination therapies) by a pharmaceutical company (alone or in collaboration with other partners) for an indication. A program consists of a set of clinical trials with the ultimate goal of approval for marketing. Each program has unique and specific parameters that can potentially justify a separate regulatory approval. Specifically, the definition of a clinical program is one of unique drug(s), drug dosage, mode of administration, adjuvant state, indication, sponsor, disease severity (e.g. stage of disease), line of treatment and biomarker information used as inclusion criteria.
**This material is provided for informational purposes only, and it is not, and may not be relied on in any manner as investment advice or as an offer to sell or a solicitation of an offer to buy an interest in any fund or investment vehicle managed by Intelligencia AI or any other Intelligencia entity. The information and data are as of the publication date unless otherwise noted, and Intelligencia has no obligation to update such information or data. Certain information contained herein has been obtained from third-party sources. Although such content is believed to be reliable, it has not been independently verified as to its accuracy or completeness and cannot be guaranteed.